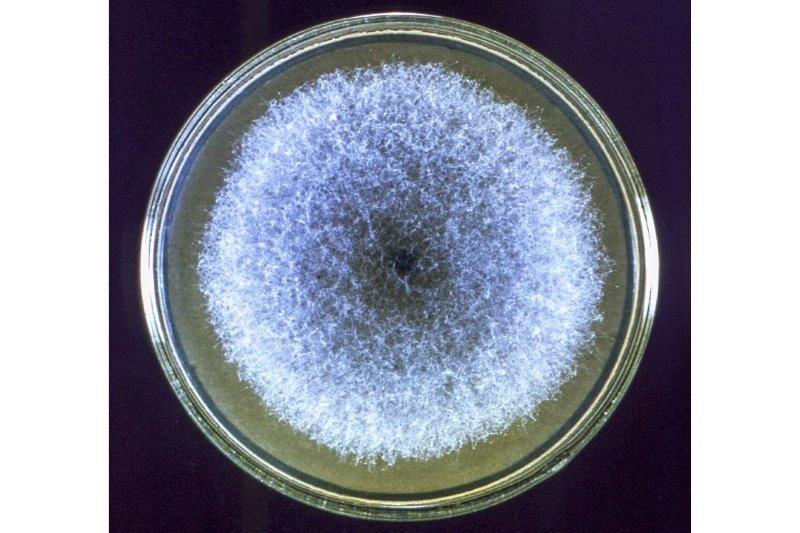

Equitable Māori eye health in practice
Ocular health disparities between Māori and non-Māori are well-recognised1, with current epistemologies of Western medicine failing to acknowledge the holism of Māori health. Kaupapa Māori methodologies are important and help ensure Māori receive healthcare that reflects their principles and values and is culturally responsive2. However, more research is needed to investigate the best ways to clinically apply kaupapa Māori principles to achieve tangible and meaningful change3.
Since limitations in workforce diversity currently preclude a widespread ‘by Māori, for Māori, with Māori’ approach to clinical care, research by Auckland’s Ocular Surface Laboratory team has been exploring whether an enhanced patient experience can be achieved by applying nine key kaupapa Māori principles within a standard eye exam delivered by Māori or non-Māori clinicians. These principles are described in the Ngā Mata O Te Ariki: Ocular Health Engagement (NMOTA) framework, developed in 2022 at the University of Auckland as BMedSci honours research led by Isaac Samuels.
Here, we describe early outcomes from a research project which began in 2022. It was designed to assess the clinical application of principles such as whakawhitiwhiti kōrero (high quality communication/relationship building), mana tangata (upholding the power/authority of an individual) and taha wairua (spiritual health), among others. Qualitative analysis showed application of the framework in the eyecare setting was overwhelmingly supported by Māori participants, while non-Māori individuals from diverse ethnic backgrounds also generally responded positively. This is encouraging when considering the likelihood of widespread acceptance of such a framework.

Isaac Samuels with supervisor and mentor Dr Mataroria Lyndon, senior lecturer in medical education at the University of Auckland
Quantitative analysis is underway, with preliminary findings suggesting higher satisfaction levels in both Māori and non-Māori participants when the framework is implemented, irrespective of the ethnicity of the practitioner delivering the eyecare. It’s hoped that such improved patient satisfaction might ultimately translate to more active patient engagement with health services and greater patient attendance at follow-up visits.
Participants also reported being much more likely to refer whānau (extended family), which could prove particularly beneficial for Māori communities, helping to reduce uncertainty and foster positive decision-making4. This mahi (work) ultimately aims to tackle elements which perpetuate and exacerbate Māori health inequities. By fostering greater engagement, it’s hoped earlier diagnosis and enhanced eyecare across Māori communities will be promoted.
References
1. Samuels I, Pirere J, Muntz A, Craig J. Ngā whakāro hauora Māori o te karu: Māori thoughts and considerations surrounding eye health. Clin Exp Optom. 2022 Dec 12;1–7.
2. Rolleston A, Cassim S, Kidd J, Lawrenson R, Keenan R, Hokowhitu B. Seeing the unseen: evidence of kaupapa Māori health interventions. AlterNative (Nga Pae Maramatanga (Organ). 2020 Jun;16(2):129–36.
3. Smith L. Decolonizing Methodologies: research and Indigenous peoples. 2nd ed. 533 Castle Street, Dunedin: Otago University Press; 2012.
4. Bikhchandani S, Hirshleifer D, Welch I. A theory of fads, fashion, custom, and cultural change as informational cascades. J Polit Econ. 1992 Oct;100(5):992–1026.

Isaac Samuels, currently a final year Māori medical student at Middlemore Hospital, completed his BMedSci Honours project in the OSL under the supervision of Professor Jennifer Craig in 2022.

Jordan Cooper is a fourth-year BOptom (Hons) student who recently completed a summer studentship with the OSL team at the University of Auckland.